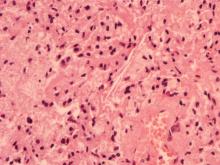
圖2：肺之局部肉芽腫病灶中可見以單核球及巨大細胞為主之炎症細胞浸潤，另可見膽固醇裂隙。

懶猴全身性黴菌感染症
- 英文名稱
- Systemic Mycosis in a Monkey
- 作者
- 盧泰志 ;鄭昉苓 ;李煥勳 ;李淑慧; 張國慧;林進忠
- 建立日期
- 96年01月18日
- 更新日期
- 96年01月18日
- 內容
一、 病歷: 89年10月11日下午,由本市市民陳太太蒞所申請斃死懶猴(Nycticebus coucang)乙隻之病性鑑定業務,據其稱述該猴于前晚並無顯示任何異狀,然于隔日(10月10日)晨即發現斃死于其窩中,隨即將之包裹後置於冷凍櫃中暫存並于今日送至本所。經詢問病史得知該猴已飼養九年餘,甚少外出,家中另飼有博美狗乙頭與其為伴。近兩個月來食慾不如已往而出現逐漸削瘦、精神不佳之現象且排出之尿液色濃並味重。因其觀察該猴之齒結石嚴重且牙齦偶有出血,懷疑為牙周病造成消化不良所致。 二、 肉眼病變:
1.
天然孔:口腔內有嚴重之齒結石。 2.
淋巴結:雙側之下顎淋巴結有腫大現象;腰淋巴結亦有腫大、剖開後內可見有二至三個黑色圓形壞死灶。 3.
肺臟:雙葉皆有多發局部性黃白色圓形突起結節,直徑約2-4 mm大小並深入實質;肺右葉與胸壁、橫膈膜粘連。 4.
膽囊:輕微腫脹。 5.
心囊腔:心囊液增多。 6.
大腦:表面潮紅。 三、 組織病變: 1.
肺:肺水腫,局部肉芽腫病灶,壞死區內有大量炎症細胞浸潤,以單核球和巨大細胞為主。在許多Giant cell中可見褐色不易染色的黴菌菌體。局部壞死區近血管處可見膽固醇裂隙浸潤。 2.
肝:大區域瀰漫性壞死,肝索排列凌亂,多數巨大細胞浸潤,並可見多數黴菌樣菌體出現。 3.
脾與淋巴結:多發局部肉芽腫,淋巴球減少流失,大量吞噬球及巨大細胞浸潤於壞死灶,內含多數黴菌樣菌體。 4.
腦:局部肉芽腫病灶,輕度腦膜炎,在病灶區可見大量多形性單核球浸潤。 5.
橫膈膜:肉芽腫,大量單核球浸潤,內含黴菌樣菌體。 四、 實驗室檢驗: 1.
寄生蟲檢驗:刮取大腸黏膜壓片作鏡檢未發現有寄生蟲或蟲卵。 2.
細菌檢驗:剪取肺臟組織乙塊,直接塗抹于MacConkey agar及Blood agar plate上並培養于37℃恆溫箱中,于第二天觀察時未發現有任何之菌落生長。 3.
特殊檢驗:將採取之肺臟病材送行政院農業委員會家畜衛生試驗所委請進行結核分枝桿菌之培養,結果尚未得知。 五、 診斷: 懶猴全身性黴菌感染症(Systemic Mycosis in a Monkey) 六、 討論: 本病例之全身性黴菌感染,雖未能分離出病原菌,然依病理組織切片中之形態學、染色特性及臨床症狀,推判可能為隱球菌感染症(Cryptococcosis)。一般而言,隱球菌症常須與惡性瘤作區別,其特好發于肺及中樞神經系統之病變則類似于結核病或其他類之黴菌性感染症。由隱球菌所引致之腦膜炎其病程較結核病所引起者為長而近似于由布氏桿菌或李斯特菌所感染引起之腦炎。 在狗及貓如有迷走神經及非特殊病徵之中樞神經系統或呼吸系統之疾病,尤其伴隨有鼻漏症狀時,應考慮為本病之感染。在貓其症狀更似胸型之惡性淋巴瘤,其表面結節常致其吞嚥困難,而狗亦同。有時狗之隱球菌感染會造成持續性的耳炎並有頑固性之口及鼻部病灶,類似于其他呼吸系統方面的黴菌性感染。 在牛的乳腺感染上須與其他的細菌感染(如黴漿菌、奴卡氏菌)作區別,而偶有其他類酵母菌(如Candida,Geotrichum,Trichosporon)引起之乳房炎亦須由其菌絲及孢子之生長形態來作鑑別。 在馬的隱球菌感染症中呼吸失調是最常見之症狀,並伴有鼻漏。其須以Mucicarmine染色法與phycomycosis及Rhinosporidiosis作區別,雖然Rhinosporidium seeberi其莢膜染色亦為陽性,但可由形態學上與隱球菌作一區分。 七、 討論: 隱球菌(Cryptococcus spp.)為直徑約5~20μm,球形、厚膜、單發芽的酵母菌,圍繞了一圈很寬且有折光性之膠狀莢膜。在Sabouraud dextrose agar或BAP上,于室溫或37℃環境下可生長,初次分離培養時間約2~4天內可出現菌落,但有時會遲至10~14天才有菌落生長。最初的菌落呈乳油色,隨後變成淡黃色且黏液性。不具醣類醱酵能力,尿素反應為陽性。在組織中呈出芽生殖、有很寬的透明莢膜以及在室溫下無菌絲及內孢子產生等均可做為判別佐證。 隱球菌病則為亞急性或慢性散發性非接觸感染的疾病。病原為新型隱球菌(Cryptococcus neoformans),在致死性的全身感染病例中亦可侵入肺及皮膚,特別偏好腦及腦脊髓膜等組織。本病為世界性的分佈,感染的動物包括人、猴、馬、牛、豬、犬、貓、印度豹以及雪貂等。本菌為腐物寄生菌,可由土壤、果實、牛乳中分離,但被認為重要的來源則存在於長久堆集的鴿子糞便中,有報告指出,亦可在鴿子的腸道內容物中分離到該菌,但在鴿子的腸管中因體溫高而不會增殖。 本菌在人類可引起原發性肺臟感染,然後由血流分佈於其他組織及器官中。最常見的臨床症狀為腦膜炎,其次為肺部、腦部之膿腫或肉芽腫,病變部呈黏膠狀,含有很多病原菌。病程可延至數年之久,未治癒的病例最後會致死。在馬的肺臟及鼻道內黏液瘤樣的病灶中可分離到本菌,在臨床上顯示持續性的呼吸不暢、鼻分泌液增加以及唇部病灶等。在牛所引起的隱球菌性乳房炎,臨床上可見乳房腫脹硬感以及局部淋巴結腫大,大部份的病例泌乳量呈顯著減少,乳汁外觀異常。犬的隱球菌病通常引起中樞神經障礙性的行動不協調,感覺過敏以及鼻漏增加;另引起口和皮膚的病灶和耳朵、臉與腳周圍的皮下肉芽腫等亦曾報告。貓的病例尤以老年的貓常顯示慢性的鼻與眼屎排出。在鼻、肺及中樞神經系統曾報告過有增生性的病灶以及肺部的肉芽腫;如病灶由鼻延伸到視神經常可導致失明。 本病例之患畜年歲已屆高齡,故其免疫能力或有不足,加之台灣氣候長年多濕,黴菌長在於環境當中,皆為感染本病之可能因子。然其實際之致病機轉為何?尚祈專家學者指正。 八、 參考文獻: 1.
劉振軒、何逸僊、張文發、祝志平、王琇真。組織病理染色技術與圖譜。100-106,
109-112, 179-181。1996。2.
蔡文城。微生物學第三版。P.613-649。1996。 3.
蔡文城。實用臨床微生物診斷學第四版。822-835。1987。 4.
劉榮標。獸醫微生物學(下冊)。907-911。1984。 5.
楊辰夫譯。臨床微生物診斷學修訂版。250-251。1979。 6.
Quinn PJ, Carter ME, Markey B, Carter GR. Clinical Veterinary Microbiology. 398-400, 1994. 7.
Carter GR. Diagnostic Procedures in Veterinary Microbiology. Second edition. 224-228, 1987. 8.
Carter GR. Essentials of Veterinary Bacteriology and Mycology, Third edition. 233-234, 1986. 9.
Paul F. Jungerman, Robert M. Schwartzman. Veterinary Medical Mycology. 139-156, 1972. .jpg)